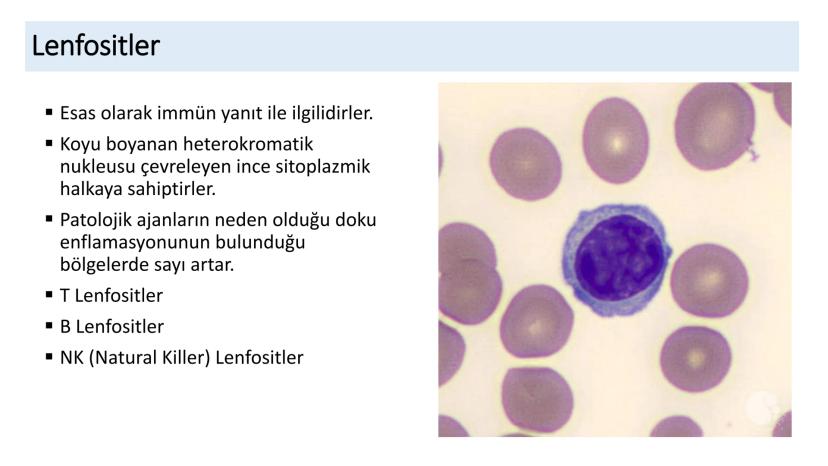
Page 19
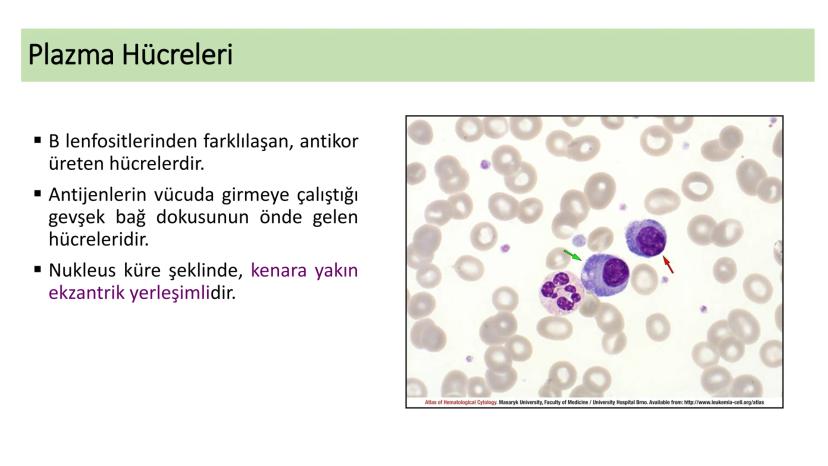
Page 21
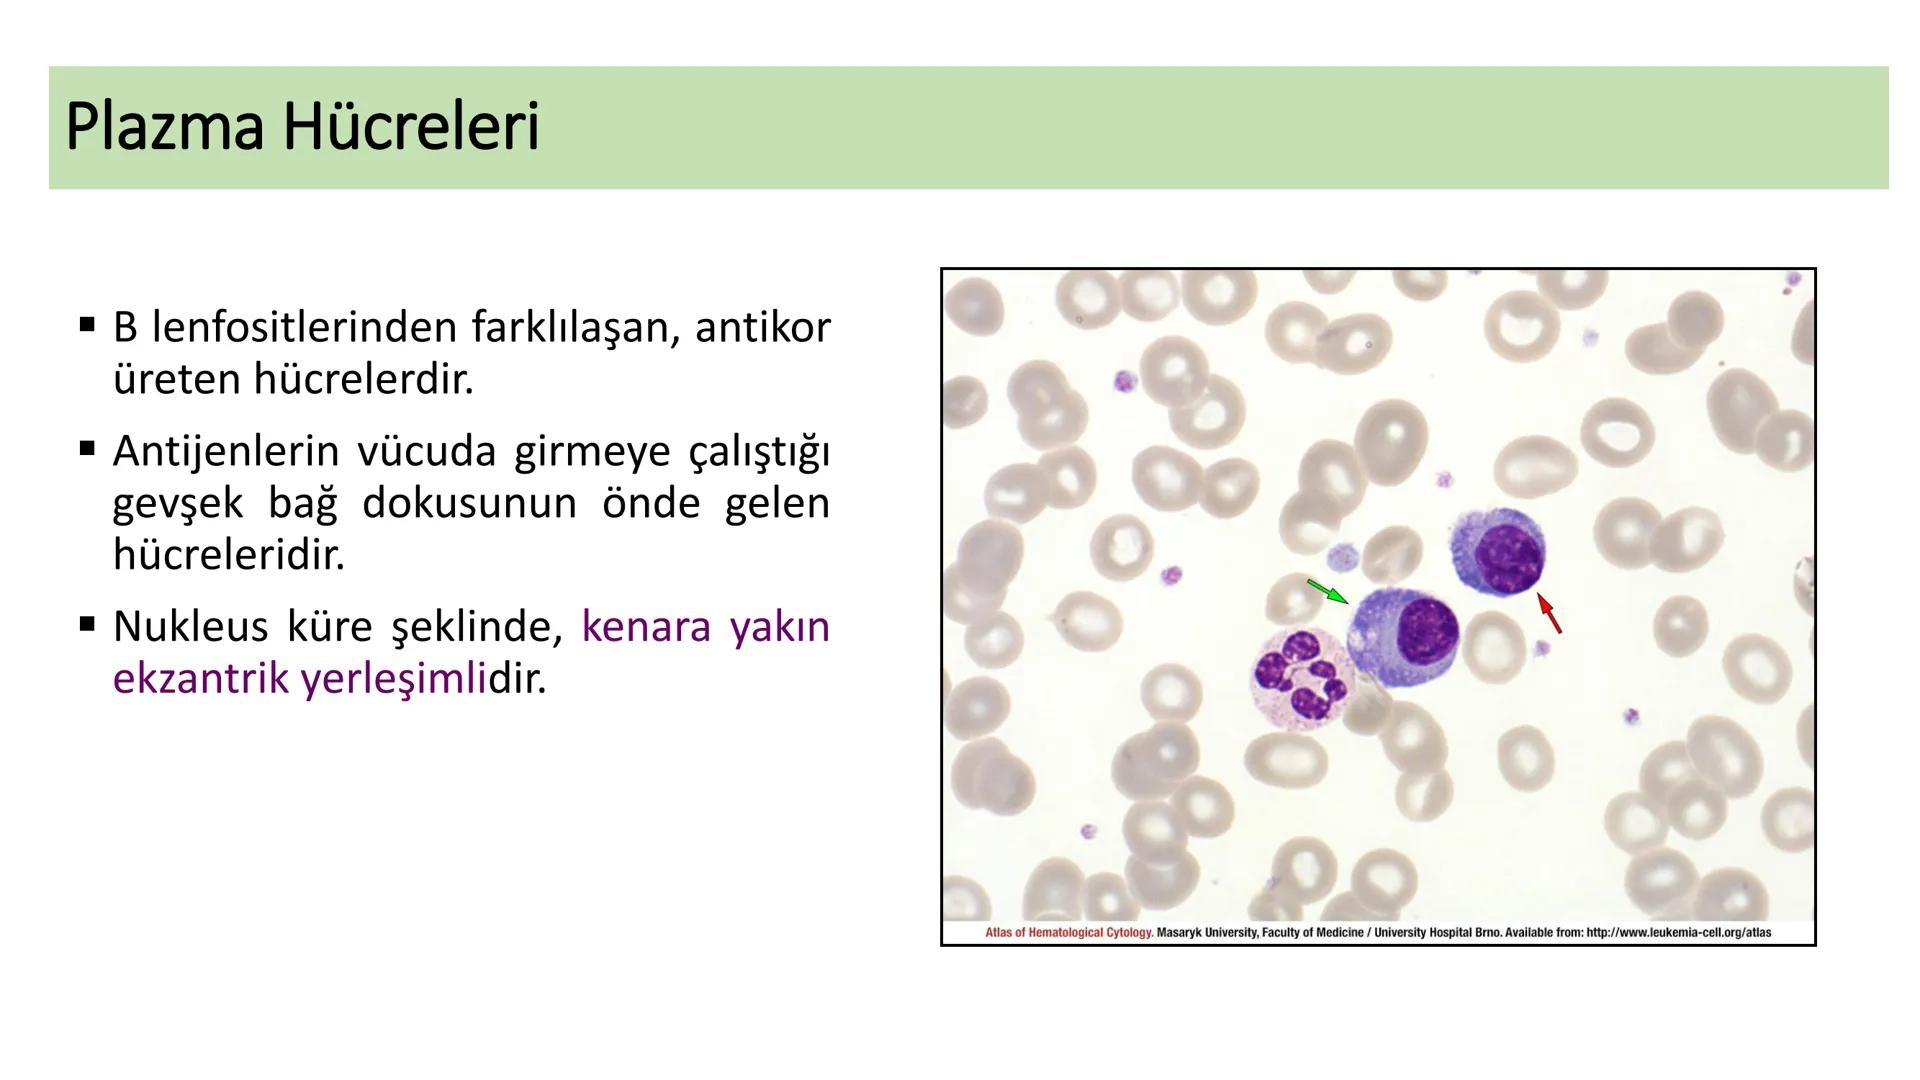
BAĞ DOKU
Doç. Dr. Sanem SARIBAŞ
SBÜ Gülhane Tıp Fakültesi
Histoloji ve Embriyoloji AD Örtü Epiteli
Bağ Doku
Bez Epiteli Bağ doku mezoderm or

Bağ doku, vücudumuzda en yaygın bulunan ve diğer tüm dokuları... Daha fazla göster
Ders notlarını görmek için kaydolÜcretsiz!
Tüm belgeleri görebilirsin
Notlarını Yükselt
Milyonlarca öğrenciye katıl
Kaydolduğunda Hizmet Şartları ve Gizlilik Politikasını kabul etmiş olursun